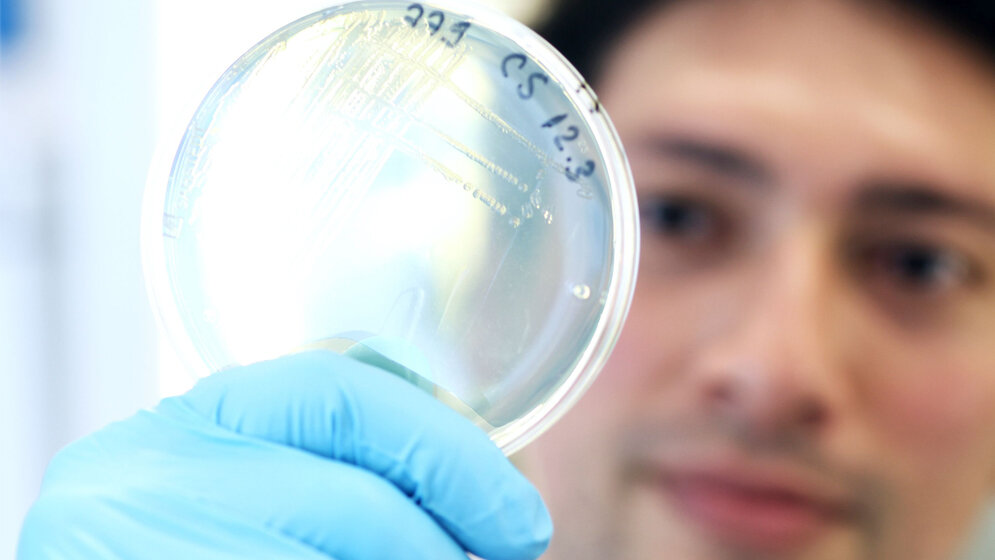
Modell zur Optimierung von Antibiotika-Kombinationen

Antibiotika-resistente Krankheitskeime könnten sich laut Aussage der Weltgesundheitsorganisation WHO innerhalb weniger Jahre zu einer der dramatischsten Gefahren für die öffentliche Gesundheit entwickeln. Während das Arsenal an wirksamen antibakteriellen Medikamenten weiter schrumpft, geht die Entwicklung neuer Wirkstoffe nur schleppend voran. Zudem kann die schnelle Evolution von Antibiotika-Resistenzen auch neue Medikamente innerhalb kurzer Zeit wirkungslos werden lassen.
Systematische, experimentelle Analyse
Wissenschaftlerinnen und Wissenschaftler hoffen in dieser bedrohlichen Situation, die Wirksamkeit der vorhandenen Antibiotika durch die gezielte Kombination bestimmter Wirkstoffeigenschaften erhalten und verbessern zu können. Ein internationales Forschungsteam um die Arbeitsgruppe Evolutionsökologie und Genetik der Christian-Albrechts-Universität zu Kiel (CAU) legt nun erstmals eine systematische, experimentelle Analyse vor, die die Wirksamkeit verschiedener Antibiotika-Kombinationen gegen den Krankheitserreger Pseudomonas aeruginosa beschreibt. Dabei fanden die Forschenden heraus, dass bestimmte Eigenschaften einer Antibiotika-Kombination entscheidend für die Effizienz der Behandlung sind. Ihr neuartiges Modell zur „Wirksamkeit von Antibiotikakombinationen“ (Englisch: „ACE – Antibiotic Combination Efficacy“) veröffentlichten die Forschenden in der aktuellen Ausgabe der Fachzeitschrift PLOS Biology.
Evolutionsexperimente mit 39 Kombinationen
Um die Auswirkungen auf den Krankheitserreger zu untersuchen, führte Dr. Camilo Barbosa, wissenschaftlicher Mitarbeiter in der Arbeitsgruppe Evolutionsökologie und Genetik an der CAU, Evolutionsexperimente mit 39 Kombinationen von zwölf verschiedenen Wirkstoffen durch. Bis zu zehn Tage setzte er die Bakterien den verschiedenen Medikamentenpaaren aus und beobachtete das Wachstum der Bakterienkulturen und mögliche Resistenzbildungen im Verlauf der Zeit. In insgesamt 1.600 einzelnen Evolutionsexperimenten konnte er so systematisch die Wirkung der Medikamentenkombinationen auf die Bakterien und die dabei stattfindenden Interaktionen zwischen den Wirkstoffen dokumentieren. Anschließend wendete er eine Kombination verschiedener statistischer Verfahren an, um die evolutionäre Anpassungsfähigkeit der Keime – das wichtigste Hindernis für den Erfolg herkömmlicher Kombinationstherapien – auch theoretisch vorhersagen zu können.
Zwei Hauptfaktoren identifiziert
Auf diesem Wege konnte Barbosa gemeinsam mit seinen Kollegen zwei Hauptfaktoren identifizieren, die für eine verbesserte Wirksamkeit der Kombinationstherapie ausschlaggebend sind: Einerseits erwiesen sich sogenannte synergistische Effekte zwischen den Wirkstoffen als vielversprechend, da sie gegenseitig ihre Wirkung verstärken und so für eine gesteigerte Ausrottung des Krankheitserregers sorgen. Zusätzlich ist die Nutzung der sogenannten kollateralen Sensitivität von Vorteil, bei der die Abwehr des Bakteriums gegen einen Wirkstoff es zugleich empfindlich für das zweite Medikament macht. Dieses Phänomen hatte Barbosa gemeinsam mit Kolleginnen und Kollegen erst kürzlich in einer Vorgängerarbeit genauer beschrieben. Eine Antibiotika-Paarung, die eine synergistische Wirkung mit dem Effekt der kollateralen Sensitivität vereint, ist demnach am effektivsten und verspricht den größten Behandlungserfolg: Im Labor ließen sich die Bakterien so am besten dezimieren, während sie zugleich eine drastisch reduzierte Resistenzbildung zeigten.
„Mit dem ACE-Modell beschreiben wir erstmals einen vielversprechenden Weg, um die Eigenschaften von Medikamentenpaaren besonders wirkungsvoll zu kombinieren. So wollen wir dabei helfen, die Bekämpfung bakterieller Infektionen künftig gezielter und nachhaltiger zu gestalten“, betont Professor Hinrich Schulenburg, Leiter der Arbeitsgruppe und Sprecher des Kiel Evolution Center (KEC). Die jetzt vorgelegte Studie zeige zudem erneut, dass ein erfolgreicher Kampf gegen Antibiotikaresistenzen nur gelingen könne, wenn die zugrundeliegenden evolutionären Prinzipien in die Behandlungsstrategie einbezogen würden, so Schulenburg weiter.
Bakterienbefall und Resistenzbildung mindern
In den Experimenten mit Pseudomonas aeruginosa zeigten sich diese positiven Effekte am deutlichsten bei der Kombination von Antibiotika der Wirkstoffklassen der Penicilline und Aminoglykoside. In den Laboruntersuchungen bewiesen sie eine ausgeprägte gegenseitige Verstärkung ihrer Wirkung auf den Keim, während die kombinierte Anwendung die Resistenzbildung des Keims hemmte. So konnte das Kieler Forschungsteam aufzeigen, wie sich durch eine optimierte Wirkstoffkombination zugleich der Bakterienbefall und die Wahrscheinlichkeit der Resistenzbildung im Falle einer Infektion drastisch mindern lassen. In weiteren Forschungsarbeiten wollen die Wissenschaftlerinnen und Wissenschaftler nun klären, ob diese beiden für den Behandlungserfolg entscheidenden Faktoren auch auf andere Krankheitserreger und insbesondere die Behandlung von Menschen übertragbar sind. Langfristiges Ziel der Forschenden des KEC ist es, alternative und nachhaltige Strategien für den klinischen Behandlungsalltag zu entwickeln und so mögliche Wege aus der Antibiotikakrise aufzuzeigen. (idw, red)
Camilo Barbosa, Robert Beardmore, Hinrich Schulenburg and Gunther Jansen (2018): Antibiotic combination efficacy (ACE) networks for a Pseudomonas aeruginosa model. PLOS Biology, Published: April 30, 2018, DOI: 10.1371/journal.pbio.2004356.
Artikel teilen